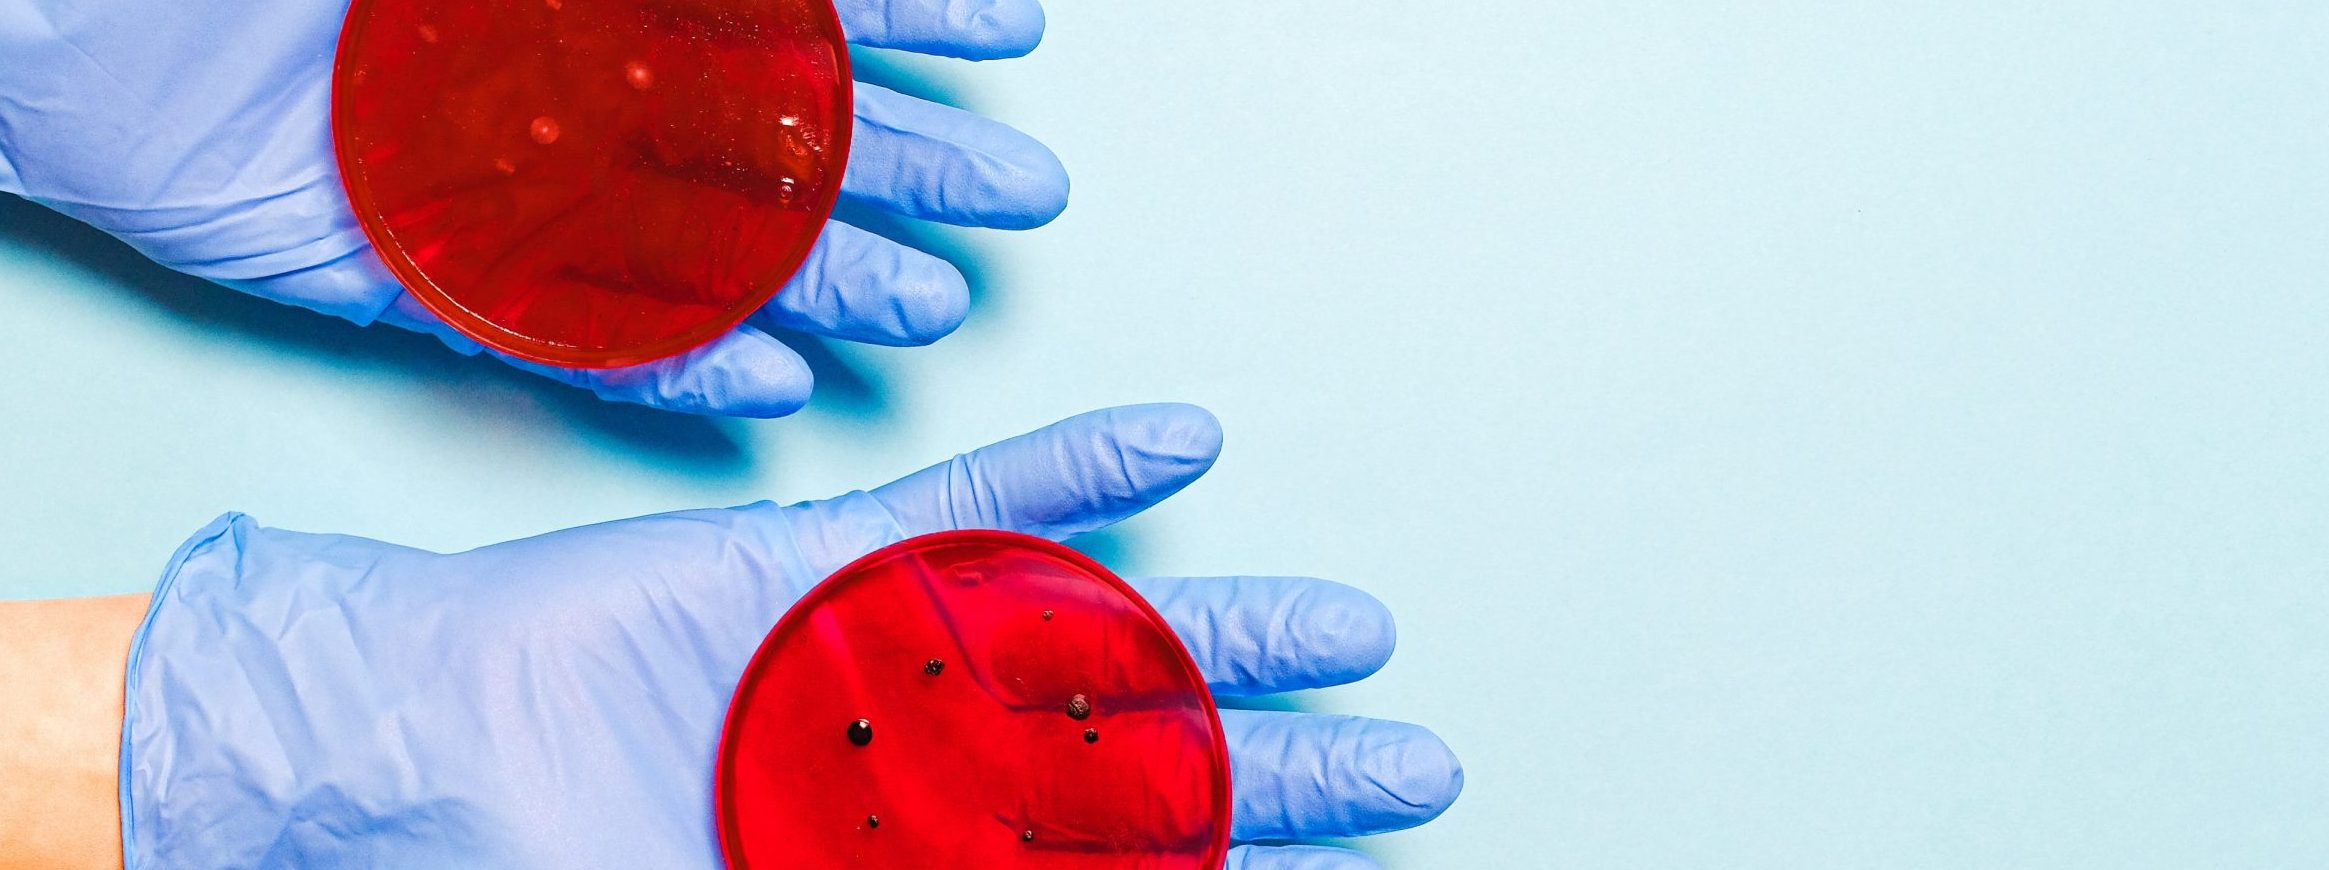

Het aantal verkochte soa-zelftesten is flink toegenomen tijdens de coronapandemie. Hoewel dergelijke tests een uitkomst zijn voor mensen die schromen naar de dokter of GGD te gaan, is Soa Aids Nederland niet onverdeeld enthousiast.
SOA
Minder gratis soa-testen door corona
Het is dit jaar moeilijker geworden voor risicogroepen en jongeren om een gratis soa-test te ontvangen. Net als tijdens de eerste lockdown is het aantal soa-consulten bij de GGD in Amsterdam afgenomen, blijkt uit onderzoek van NAP Nieuws.
''Het blijft wel een beetje de 'walk of shame'''
NAP Nieuws bezoekt iedere editie een bijzondere plek of een speciaal persoon in Amsterdam. Altijd een overtreffende trap; de grootste, oudste, duurste … van onze hoofdstad. Deze week: de SOA-poli van de GGD, de drukstbezochte SOA-polikliniek van Amsterdam.
Onveilige seks vanwege economische crisis
Ze hebben minder klanten, terwijl de kosten flink zijn gestegen. Prostituees op de Wallen worden hard getroffen door de economische crisis. Sommigen kiezen door de inkomstendaling zelfs voor de illegale prostitutie.
Zomaar binnenlopen bij de soa-poli kan niet meer
Steeds meer Amsterdammers lopen een soa op. Maar de GGD polikliniek aan het Weesperplein ontmoedigt de vrije inloop voor soa-testen. Sinds half 2008 loopt het aantal consulten – na jaren van flinke toename – terug. AMSTERDAM – Het is stil voor de GGD polikliniek aan het Weesperplein op donderdag rond acht uur ‘s ochtends. Slechts […]